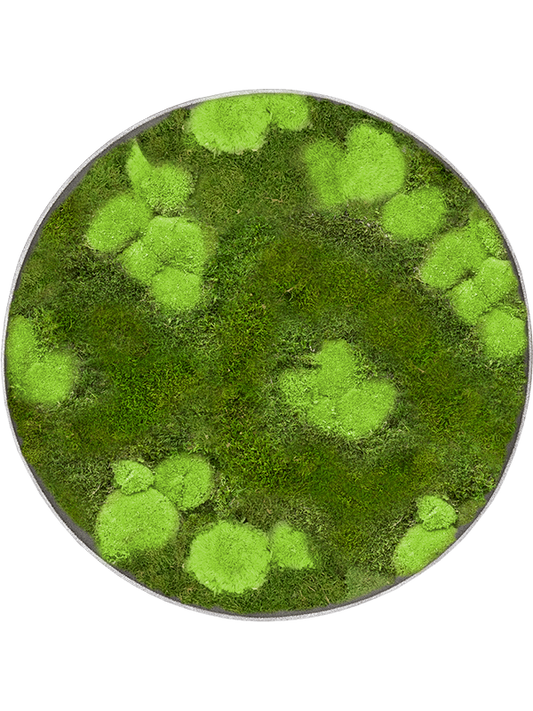
Moosbild

Kategorie: Baby-Pflanzen
-

 Ausverkauft
AusverkauftAglaonema Pictus Tricolor
Normaler Preis CHF 19.90Normaler PreisGrundpreis / pro -
 Ausverkauft
AusverkauftHoya Australis Tricolor
Normaler Preis CHF 9.90Normaler PreisGrundpreis / pro -
Myrtillocactus
Normaler Preis CHF 5.90Normaler PreisGrundpreis / pro -
Cactus overig
Normaler Preis CHF 9.50Normaler PreisGrundpreis / pro -
Schefflera arboricola
Normaler Preis CHF 7.90Normaler PreisGrundpreis / pro -
Ficus benjamina
Normaler Preis CHF 19.90Normaler PreisGrundpreis / pro -

 Ausverkauft
AusverkauftSchefflera
Normaler Preis CHF 29.00Normaler PreisGrundpreis / pro -
Aloë zebrina
Normaler Preis CHF 25.00Normaler PreisGrundpreis / pro -

 Ausverkauft
AusverkauftHasenohrkaktus
Normaler Preis Von CHF 15.90Normaler PreisGrundpreis / pro -
 Ausverkauft
AusverkauftDieffenbachia Snow
Normaler Preis CHF 17.50Normaler PreisGrundpreis / pro -

 Ausverkauft
AusverkauftDieffenbachia seguine
Normaler Preis CHF 79.50Normaler PreisGrundpreis / pro -

 Ausverkauft
AusverkauftClusia Rosea
Normaler Preis CHF 21.50Normaler PreisGrundpreis / pro -
 Ausverkauft
AusverkauftMonstera Obliqua Peru
Normaler Preis CHF 49.00Normaler PreisGrundpreis / pro -
 Ausverkauft
AusverkauftSchefflera
Normaler Preis CHF 19.90Normaler PreisGrundpreis / pro -
Blaukaktus
Normaler Preis CHF 25.50Normaler PreisGrundpreis / pro -
 Ausverkauft
AusverkauftTrachelospermum jasminoides - Jasmin
Normaler Preis CHF 43.00Normaler PreisGrundpreis / pro -
Olea Europaea - Olivenbaum
Normaler Preis CHF 75.00Normaler PreisGrundpreis / pro
Let customers speak for us
from 27 reviewsDie Alocasia Scalprum, die ich von Mahalo Plants bekommen habe, ist wirklich etwas Besonderes. Die Blattform ist einzigartig und die Pflanze kam in einwandfreiem Zustand bei mir an. Sehr gesund, gut verpackt und einfach ein Hingucker! Ich freue mich jedes Mal, wenn ich sie anschaue. Klare Weiterempfehlung!

Meine Glückskastanie von Mahalo Plants hat mich wirklich positiv überrascht. Sie kam gut geschützt, in bestem Zustand und mit kräftigem, gesundem Wuchs an. Man sieht, dass sie mit Sorgfalt gezogen wurde. Sie macht sich wunderbar in meinem Zuhause – gerne wieder!

Ich habe einen Ficus benjamina ‘Twilight’ von Mahalo Plants gekauft und bin sehr zufrieden! Die Pflanze war gesund, schön gewachsen und kam in einwandfreiem Zustand an. Klare Empfehlung – ich würde hier jederzeit wieder kaufen!

Sehr schöne Pflanze, die den Erwartungen und Angaben entspricht. Pflanze sieht gesund aus und ist, sicher verpackt, wohlbehalten angekommen.

Ich habe die Kaffeepflanze in einer sehr sorgfältigen Verpackung erhalten. Die Pflanze war in einem ausgezeichneten Zustand und vollkommen gesund. Ich bin sehr zufrieden mit dem Kauf!

Die Alokasie ist sehr schön und gesund. Sie kam gut verpackt an und sieht toll aus. Ich würde sie auf jeden Fall weiterempfehlen!

Schöne, gesunde Pflanze. Gut und sicher verpackt.

- Sieht sehr schön aus. Genügend "buschig".
- gut verpackt und unbeschädigt angekommen.
- Hat das Umsetzen in anderen Substrat (Pon) überlebt.
-Preis/Leistung gut
Danke!

- Gesunde, schöne Pflanze, für mich auch genügend "variagation". Die Umtopfung hat sie auch überlebt einen neuen Blatt schon gekriegt und der zweite ist unterwägs.
- Perfekt verpackt.
- Preis/Leistung: gut
Herzlichen dank.

Top Service, schnell, offene Kommunikation.
Und sehr vorsichtig eingepackt, damit den Pflanze währen den Lieferung nicht kaputt geht. Immer wieder gern.

Die Pflanze entspricht dem Bild.
Sie wurde sehr sicher verpackt (mit Heatpack) und ist dementsprechend auch ohne Probleme gutaussehend angekommen. Neues Wachstum ist klar sichtbar und die Wurzeln waren auch gesund.

Die Pflanze kam sicher und gut verpackt an, sie macht einen gesunden und gepflegten Eindruck und sie hat ihren Platz gefunden. Kommt schön zu Geltung.